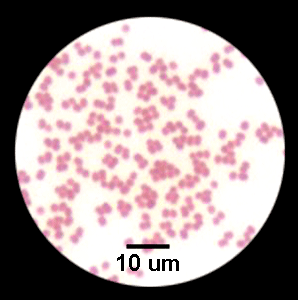
卡他莫拉菌肺炎

卡他莫拉菌3

卡他莫拉 莫拉菌属(moraxella)与不动杆菌属同属莫拉菌科,共有15个种.
图片尺寸1920x2037
每日一种菌 卡他莫拉菌 原为布兰菌属后划分为莫拉菌属 各位微生物的
图片尺寸1440x1920
卡他莫拉菌(mc) 涂片染色:革兰阴性球菌,无芽孢,无鞭毛.
图片尺寸1280x1280
卡他莫拉菌
图片尺寸1575x1162
卡他莫拉菌
图片尺寸1500x1125
卡他莫拉菌
图片尺寸1500x1125
卡他莫拉菌
图片尺寸1920x2297
卡他莫拉菌(首次发现于1896年的病菌)_尚可名片
图片尺寸981x717
卡他莫拉菌(mc)
图片尺寸1280x1280
卡他莫拉菌
图片尺寸1500x1125
卡他莫拉菌
图片尺寸1600x1200
卡他莫拉 莫拉菌属(moraxella)与不动杆菌属同属莫拉菌科,共有15个种.
图片尺寸1920x2560
卡他莫拉菌
图片尺寸2000x1500
(一)卡他莫拉菌
图片尺寸960x540
卡他莫拉菌
图片尺寸1080x1439
卡他莫拉菌与奈瑟菌的简单区别
图片尺寸1080x1169
楼主乐园2013-04-05 20:45:47 卡他莫拉菌是2013年卫生部第一次室间
图片尺寸1598x1200
卡他莫拉菌
图片尺寸482x369
楼主乐园2013-04-05 20:45:47 卡他莫拉菌是2013年卫生部第一次室间
图片尺寸1500x1125
卡他莫拉菌肺炎
图片尺寸298x300